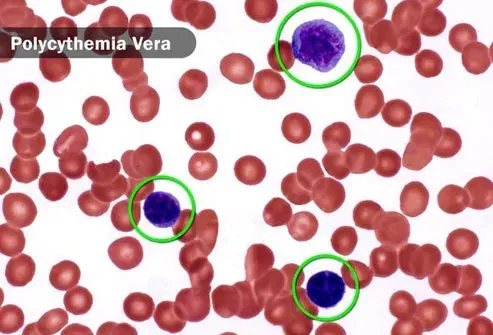
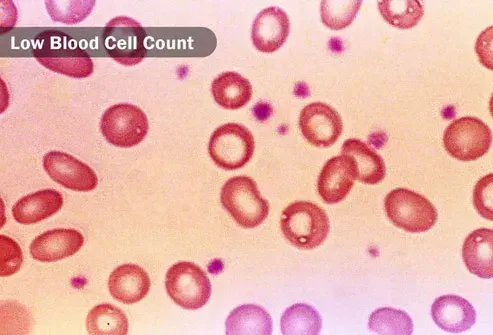

Le Informazioni Presenti Sul Sito Non Costituiscono Consulenza Medica. Non Vendiamo Nulla. L'Accuratezza Della Traduzione Non È Garantita. Disclaimer
Medicamenti
Problemi e trattamenti della pelle: motivi sorprendenti
Problemi con la tiroide

È una ghiandola nel collo che crea un ormone che aiuta il tuo corpo a conservare e bruciare energia. Se non fa abbastanza, potresti sentirti stanco debole e nebbioso. Potresti anche ottenere la pelle pruriginosa secca. È più comune nelle donne che potrebbero notare cambiamenti nel loro ciclo mensile o problemi di gravidanza. Potresti essere in grado di gestirlo con ormoni artificiali e altri trattamenti.
Gravidanza

Quando ti aspetti che il tuo corpo manda più sangue alla pelle e lo allunga sul ventre, il che può causare lieve prurito. Puoi gestirlo con abiti traspiranti sciolti bagni freschi e creme idratanti. Se il prurito è davvero male soprattutto sulle mani o sui piedi, potrebbe essere una condizione più seria chiamata colestasi. È causato da un accumulo di sali biliari dal tuo fegato. Il tuo medico guarderà da vicino te e il tuo bambino.
Diabete

I problemi della pelle sono talvolta il primo segno di questa malattia. Se hai prurito potrebbe essere un'infezione da lievito o una pelle secca tra le altre cose. Quando la circolazione è il problema, le gambe inferiori possono essere le più prurito. È importante trattare il diabete, ma puoi anche lenire il prurito se fai docce o bagni più brevi usi sapone delicato e idrata in seguito.
Cancro
Il prurito è solo raramente un segno di questa malattia ma è possibile. Un tipo di cancro al sangue chiamato policitemia vera può causarlo soprattutto dopo un bagno caldo o una doccia. Puoi anche stancarti o stuzzicare o avere difficoltà a respirare. Il cancro del pancreas può farti prurito se un tumore blocca i dotti biliari e provoca un accumulo che perde nella pelle. E pelle rossa squamosa che prurito potrebbe essere un segno di un tipo di linfoma.
Cancro Treatments

La pelle pruriginosa secca è un effetto collaterale comune della terapia mirata di radiazione chemioterapia e dei trapianti di cellule staminali. Aiuta a evitare gli irritanti della pelle come profumi e detergenti sottili e detersivi e mantenere la tua acqua calda piuttosto che calda. E ricorda di idratare subito dopo il bagno. Parla con il tuo medico di altri modi per gestire la pelle pruriginosa legata al trattamento.
Tumore

Tutto ciò che cresce sopra o vicino al midollo spinale o al tronco cerebrale può portare a prurito neuropatico. Succede quando la parte interessata del sistema nervoso non si inclina. Il medico può suggerire modi per alleviare il prurito e tenerti a graffiare troppo.
Colpo

Taglia il sangue a parte del tuo cervello. La mascella o l'orecchio della gola potrebbe prurito se colpisce i nervi cranici vicino al cervello e al midollo spinale. E il danno a determinati tessuti cerebrali può causare prurito attraverso il nervo del trigemino nel viso. Questo può portare alcune persone a graffiare fino a quando non fanno gravi danni alla pelle intorno alla guancia e al naso.
fantastico viaggio su strada americano
Herpes zoster

Lo capisci solo se hai avuto la varicella. Insieme a un'eruzione cutanea dolorosa, il virus a volte uccide le cellule in una parte del cervello chiamato gangli sensoriali. Ciò potrebbe portare al dolore e al prurito per mesi dopo che l'eruzione cutanea è sparita. Succede in circa la metà di tutte le persone che hanno un'epidemia di fuoco anche se è più comune se la tua eruzione era sul viso o sul collo. Il trattamento può essere efficace soprattutto se avviato presto per ridurre la possibilità di complicazioni.
Sclerosi multipla

Danneggia lentamente il sistema nervoso e può causare improvvisi intensi attacchi di dolore a formicolio che brucia o prurito ovunque sul tuo corpo. La malattia può anche colpire i nervi cranici o il tessuto cerebrale che potrebbero farti prurito per periodi più lunghi nella mascella o all'orecchio della gola del viso. Il medico può suggerire medicine che aiutano a portare sollievo.
Nervo pizzicato

Questa potrebbe essere la causa se hai una patch pruriginosa senza eruzione cutanea in una sola area del tuo corpo. Può succedere in una caduta o in un incidente o perché ripeti un movimento troppo come la digitazione. Un'infezione potrebbe portare a gonfiore che preme su un nervo. A volte scompare con gli anti-infiammatori e la terapia fisica, ma potrebbe aver bisogno di un intervento chirurgico se si ha un caso serio.
Farmaci

A volte causano una reazione che ti fa risuonare. Potresti avere un'eruzione cutanea ma non sempre. A volte la tua pelle sembra normale e prude comunque. I colpevoli tipici includono antimalarici di antibiotici antimalarici e farmaci per il dolore narcotico come gli oppioidi. Parla con il tuo medico prima di fermarti o cambiare la dose su qualsiasi medicinale.
Mancanza di ferro
Causa anemia, il che significa che non hai abbastanza globuli rossi. Ciò può renderti stanco debole e a corto di respiro. E la tua pelle potrebbe diventare pallida e pruriginosa. Puoi ottenere ferro da ostriche di fegato di manzo a carne rossa e cioccolato fondente. E i produttori lo aggiungono ai cereali per la colazione. Chiedi al tuo medico come evitare cibi e farmaci che rendono più difficile assorbire il ferro e scopri se gli integratori sono una buona idea per te.
Dialisi renale

È un processo di pulizia del sangue che può far risarcire la pelle in un punto o dappertutto. Troppo o troppo poca dialisi potrebbe turbare l'equilibrio nel sangue. Inoltre prende acqua extra dal tuo corpo, quindi se non bevi abbastanza la pelle potrebbe asciugarsi e innescare prurito. E a volte provoca troppo fosforo nel sangue che può legarsi al calcio e causare prurito. Verificare con il medico se noti questo sintomo.
Sindrome delle gambe irrequiete

Può sembrare che il tessuto in profondità sotto la pelle stesse strisciando strisciando formicolio o prurito. Ottieni un forte bisogno di muovere la gamba soprattutto se sei stato ancora un po '. I medici non sono sicuri di ciò che lo causa, ma potrebbe avere qualcosa a che fare con una sostanza chimica del cervello chiamata dopamina. I farmaci possono trattarlo.
Salute mentale

Lo stress d'ansia e la depressione potrebbero far sembrare più intenso qualsiasi prurito che hai da un'altra condizione. Se hai un disturbo ossessivo-compulsivo, il lavaggio delle mani o il bagno frequente può asciugare il danno e irritare la pelle. Altre condizioni potrebbero rendere più difficile smettere di graffiare, il che ti rende ancora più prurito. Fai sapere al tuo medico se ti senti ansioso o depresso o pensi che la tua salute mentale influisca sulla tua pelle.
Problemi e trattamenti della pelle: motivi sorprendenti
Fonti: 
Immagini fornite da:
levometadil acetato
- Eraxion / Thinkstock
- Dolgachov / Thinkstock
- Andreypopov / Thinkstock
- Steve Gschmeissner / Fonte scientifica
- (In senso orario dall'alto sinistra) Brianajackson Mark Kostich BDSPN / Thinkstock FNAQ / Wikimedia Commons
- stockdevil / thinkstock
- ISM / P. Marseaud / immagini mediche
- clsgraphics / istockphoto
- ktsimage / thinkstock
- 3d4dical / science fonte
- Immagini Smartstock / Getty
- Biofoto Associates / Science Fonte
- Fonte SPL / Science
- Thomas Northcut / Thinkstock
- Amana Images Inc / Getty Images
Riferimenti:
- American Diabetes Association: Complicazione della pelle.
- Cancro.net: 'Skin Conditions.'
- Dermatologia clinica: fattori psicosomatici in prurito.
- Problemi attuali in dermatologia: Gestione ITCH indotta da farmaci.
- Dana-Farber Cancer Institute: Sta pruocando un segno di cancro?
- Dermnetnz: Carenza di ferro.
- Healthywomen.org: Disturbi della tiroide.
- Mayo Clinic: Sindrome delle gambe irrequiete prurito (prurito) nervo pizzicato colestasi della gravidanza .
- National Kidney Foundation: Dialisi: prurito secco.
- Società nazionale per sclerosi multipla: prurito.
- National Institutes of Health Office of Dietary Integlements: Iron.
- Dolore: prurito e prurito neuropatico.
- Gravidanza Birth and Baby: 'Itching During Gravidanza.'
- Seminari in medicina cutanea e chirurgia: prurito neuropatico.
Questo strumento non fornisce consulenza medica. Vedere ulteriori informazioni: 
Questo strumento non fornisce consulenza medica. È destinato solo a scopi informativi generali e non affronta circostanze individuali. Non è un sostituto della diagnosi o del trattamento di consulenza medica professionale e non dovrebbe essere invocato per prendere decisioni sulla tua salute. Non ignorare mai la consulenza medica professionale nella ricerca di cure a causa di qualcosa che hai letto sul sito RXLIST. Se ritieni di poter avere un'emergenza medica, chiama immediatamente il medico o componi il 911.
© 1996-2025 WebMD LLC . Tutti i diritti riservati.
Fonte Slideshow su WebMD
